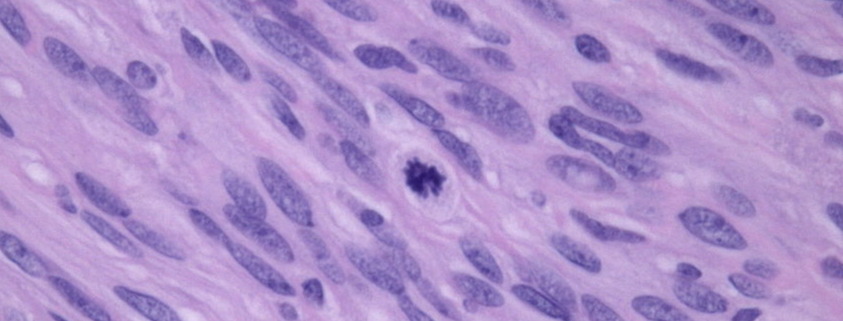
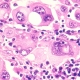

Kasvainlausunnon salat – osa 3 Gradeeraus
Kasvainlausuntoja käsittelevien blogitekstiemme ensimmäisessä osassa pureuduttiin kasvaimen kasvutavan arviointiin ja toisessa osassa tarkasteltiin kasvainsolujen piirteitä. Tässä kolmannessa osassa käydään pähkinänkuoressa läpi kasvainten gradeeraus.
Kaikki pahanlaatuiset kasvaimet eivät käyttäydy samalla tavalla ja osalla pahanlaatuisista kasvaimista voi olla varsin hyväkin ennuste. Tämän vuoksi pahanlaatuisuuden astetta arvioidaan niin sanotulla gradeerauksella. Gradeerausta käytetään nykyisin useille kasvaintyypeille ja kriteerit vaihtelevat kasvaintyyppien mukaan. Kustakin arvioidusta piirteestä annetaan pisteitä, ja yhteenlasketut pisteet määrävät kasvaimen luokan eli graden. Yleensä luokitus tehdään välillä 1-3, joista luokka 3 edustaa korkeinta pahanlaatuisuuden astetta ja on ennusteeltaan huonoin.
Gradeeraus tehdään eri kriteereillä kasvaimesta riippuen. Useimmissa kasvaintyypeissä arvioidaan solujen erilaistumista, koska erilaistumisaste vähenee kasvaimen pahanlaatuisuuden kasvaessa. Lisäksi arvioidaan solujen lisääntymisaktiivisuutta, joka useimmiten ilmaistaan niin sanotulla mitoottisella luvulla (mitotic count, eli mitoosien määrä 10 näkökentässä korkealla suurennoksella). Mitoottinen luku korreloi useimmissa tapauksissa suoraan pahanlaatuisuuden kanssa. Muita käytettyjä kriteereitä ovat esimerkiksi nekroosin esiintyminen ja laajuus sekä tumamorfologia (nuclear atypia).
Gradeerauksen avulla voidaan potilaalle usein antaa tarkempi ennuste. Valitettavasti monissa eläinten kasvainsairauksissa ennustetilastot perustuvat vain muutamaan tutkimukseen ja suppeaan aineistoon. Useiden kasvainten suhteen saadaan toivottavasti tulevaisuudessa lisää tutkimusdataa gradeerauksen korrelaatiosta kasvaimen kliiniseen käytökseen.
Tässä muutamia esimerkkejä kasvaimista, joissa gradeerausta käytetään:
- Mastsolukasvaimet: Koirien ihon mastsolukasvaimille on tällä hetkellä käytössä kaksi erilaista luokittelujärjestelmää. Näistä vanhempi on Patnaik-luokittelu, jossa mastsolukasvaimet jaetaan kolmeen luokkaan. Uudemmassa, Kiupel-luokittelussa kasvaimet jaetaan kahteen luokkaan, low-grade ja high-grade kasvaimiksi. Molempia luokitteluita käytetään yhä rinnakkain, mutta Kiupel-luokittelu on yhtenäisempi patologien välillä (inter-observer consistency). Lisäksi on hyvä huomioida, että luokittelu koskee vain kutaanisia eli ihossa esiintyviä mastsolukasvaimia eikä päde ihonalaiskudoksen kasvaimiin
- Pehmytkudossarkoomat: Koirilla ihon ja ihonalaiskudoksen pehmytkudosten sukkulasoluisia kasvaimia ei enää erotella solualkuperän mukaan, vaan niitä käsitellään yhtenä kasvainryhmänä. Kasvaimia kutsutaan yleisesti pehmytkudossarkoomiksi (soft tissue sarcoma, STS), ja niihin luetaan muun muassa hermotuppikasvaimet, fibrosarkoomat ja liposarkoomat. Histologisessa tutkimuksessa kasvaimet luokitellaan kolmeen eri pahanlaatuisuudeen luokkaan, jonka perusteella voidaan antaa tarkempaa ennustetta erityisesti paikalliselle uusiutumiselle.
- Maitorauhaskasvaimet: Maitorauhaskasvaimista esiintyy runsaasti erilaisia histologisia tyyppejä, joista osan tiedetään olevan pahanlaatuisempia kuin toisten. Saman histologisen tyypin sisällä voi myös esiintyä vaihtelua eikä kasvaimen ennuste korreloi täysin kasvaimen histologisen tyypin mukaan. Tämän vuoksi myös pahanlaatuisille maitorauhaskasvaimille on nykyään käytössä gradeeraus kolmeen luokkaan. Yhdessä histologinen tyyppi sekä gradeeraus voivat antaa tarkempaa tietoa ennusteesta.
- Uroteliaaliset karsinoomat: Uroteliaalinen karsinooma on yksi aggressiivisimmista kasvaimista eläimillä ja usein diagnosointivaiheessa kasvain on jo ehtinyt levitä. Kasvainten histologisella gradeerauksella pyritään erottamaan low-grade eli alkuvaiheen kasvaimet, jotka eivät ole vielä ehtineen levitä. Valitettavasti noin 90-95% kasvaimista luokitellaan kuitenkin high-grade kasvaimiksi, joissa nähdään jo invaasiota syvemmälle rakon seinämään ja mahdollisesti suonien sisälle.
Mikäli jokin kasvaimiin tai lausuntoihin liittyvä asia jäi askarruttamaan, ota meihin yhteyttä, Solumon eläinpatologit vastaavat mielellään!